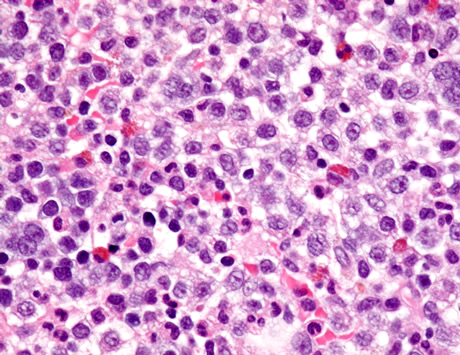
Diagnostyka i leczenie chorych na zespoły mielodysplastyczne w Niemczech

Od września do grudnia 2009 w 57 hematologicznych ośrodkach w Niemczech (9 szpitalach uniwersyteckich, 25 publicznych szpitalach i 23 ośrodkach prywatnych) przeprowadzono ankietę na temat leczenia pacjentów z MDS.
Materiał przeznaczony wyłącznie dla pracowników służby zdrowia
Ten materiał jest dostępny dla zarejestrowanych użytkowników.
Zaloguj się
Szanowni użytkownicy,
część materiałów udostępnianych na naszym portalu jest przeznaczona
wyłącznie dla lekarzy.
Wynika to z regulacji prawnych, do których musimy się stosować.
Jeśli nie jesteś lekarzem, zachęcamy do korzystania z przygotowanych przez nas materiałów dostępnych w zakładce dla pacjentów.